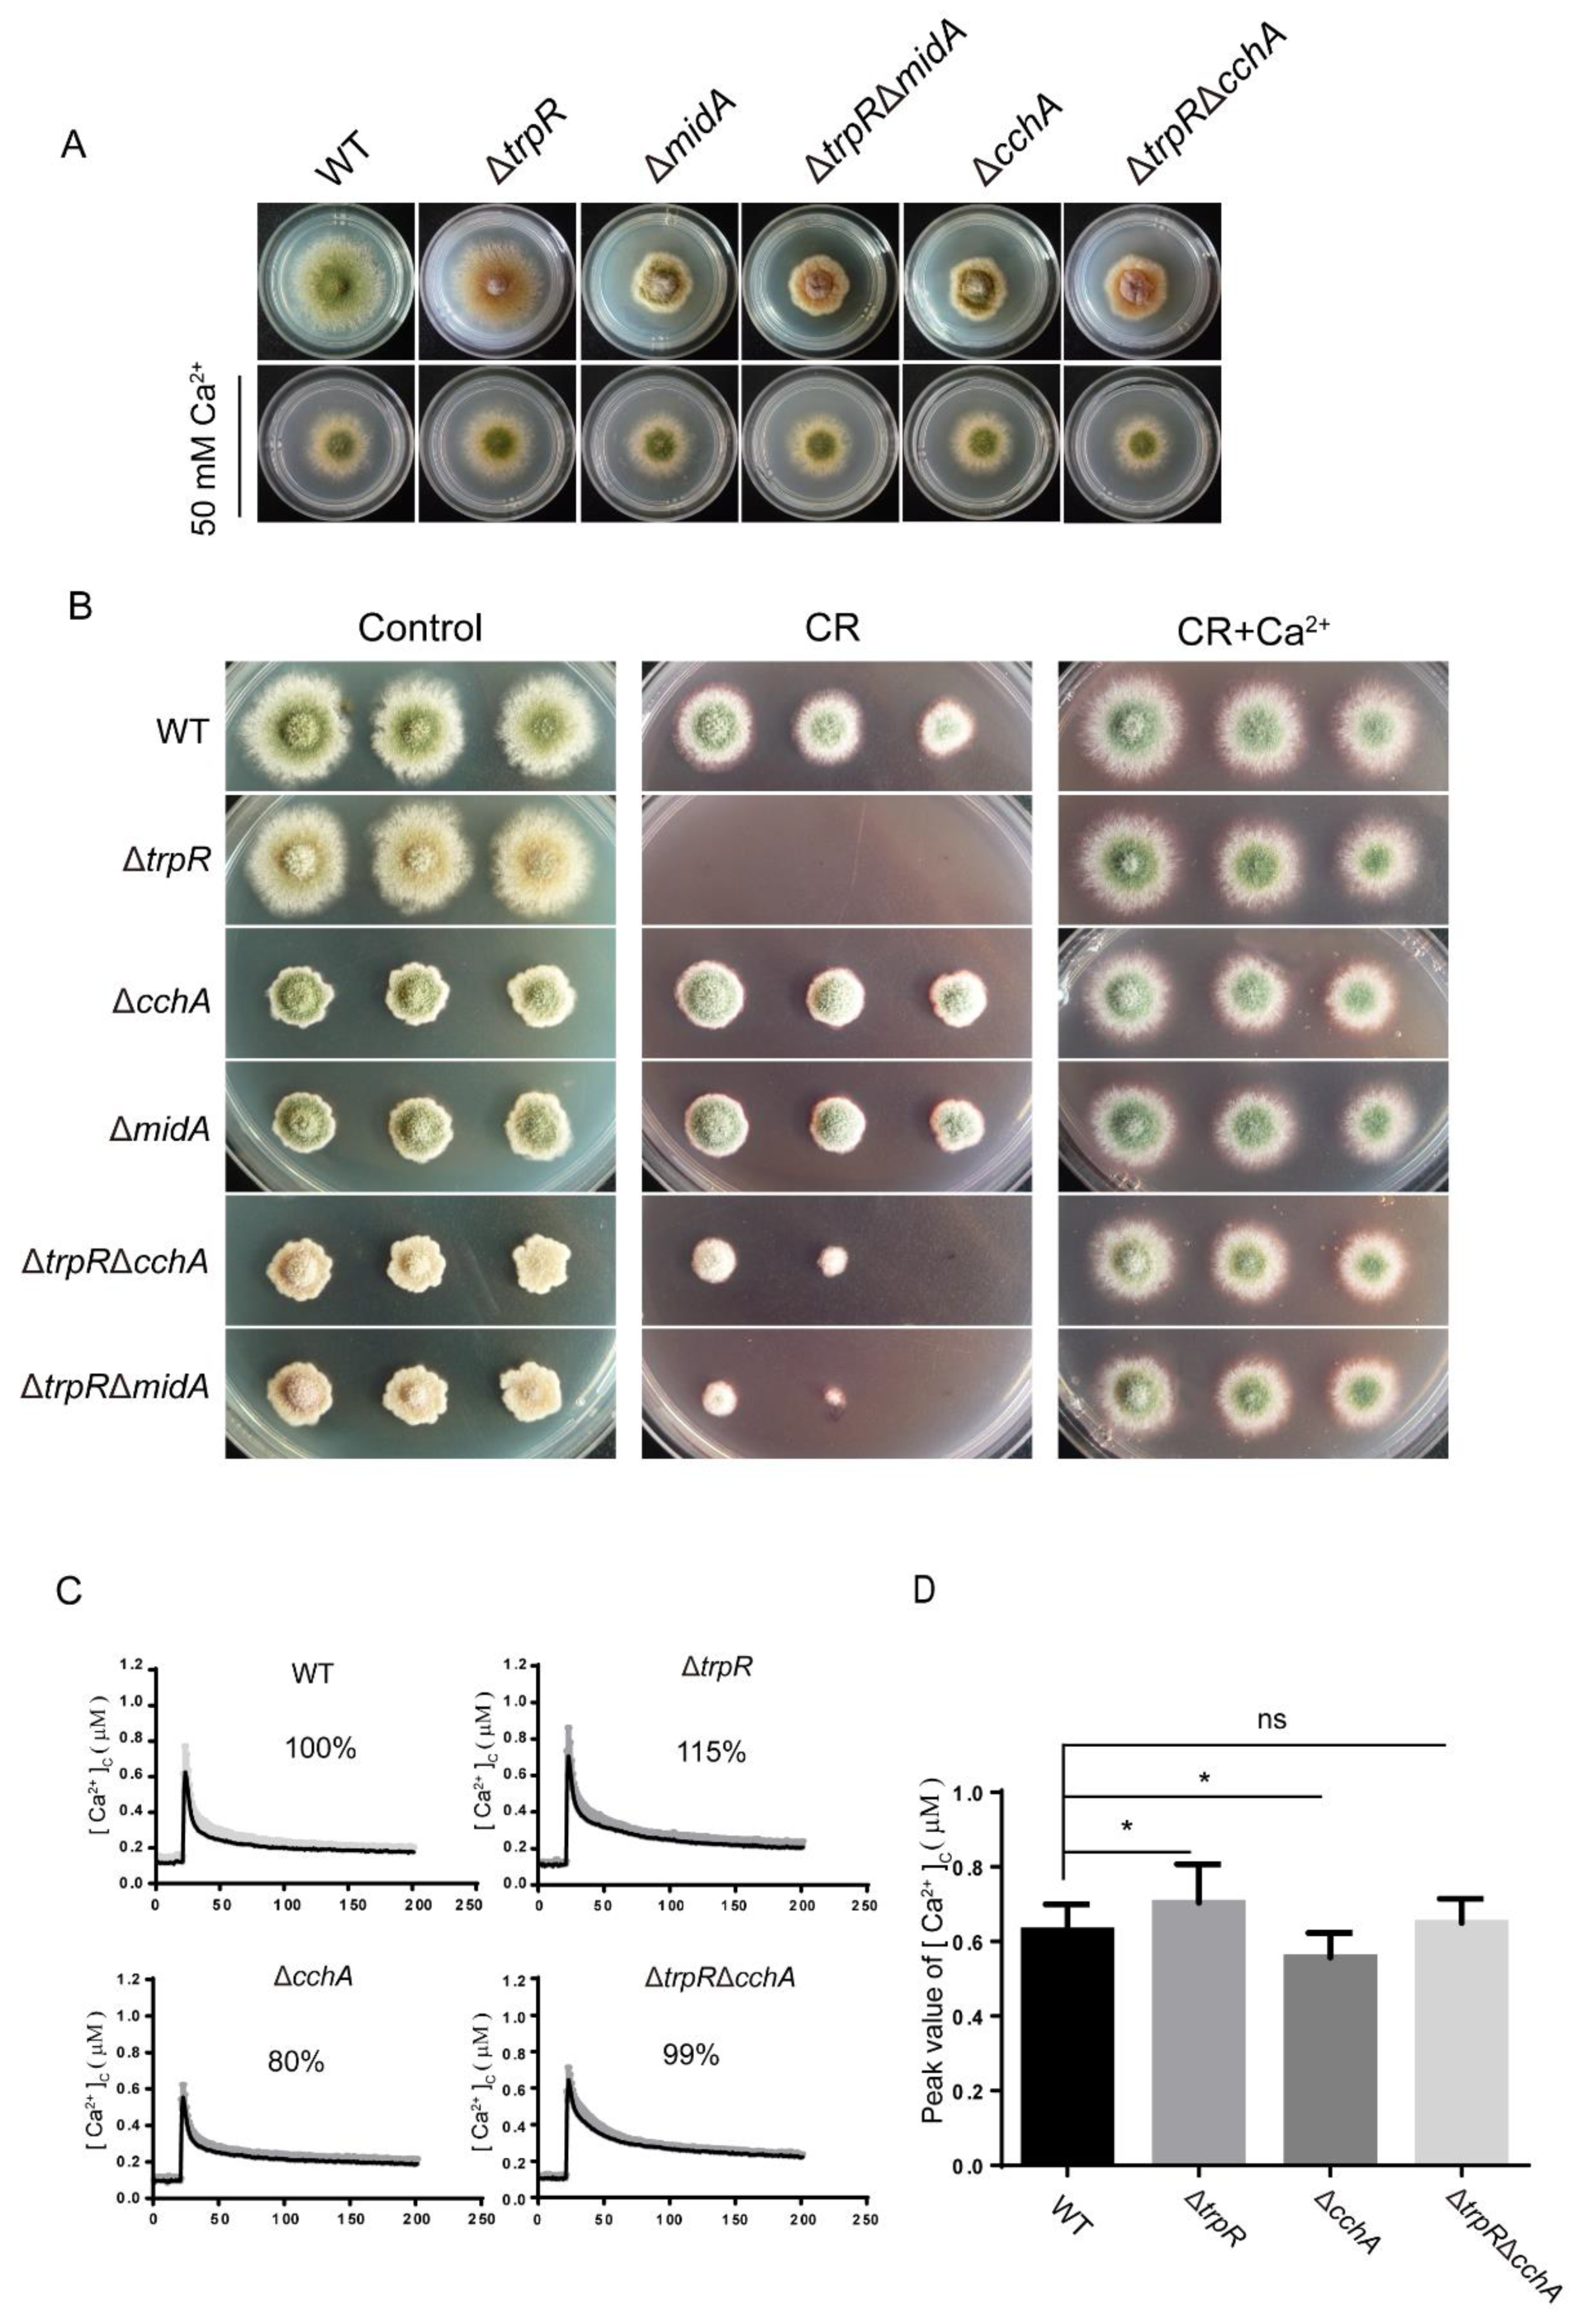
Jof 07 00920 g005
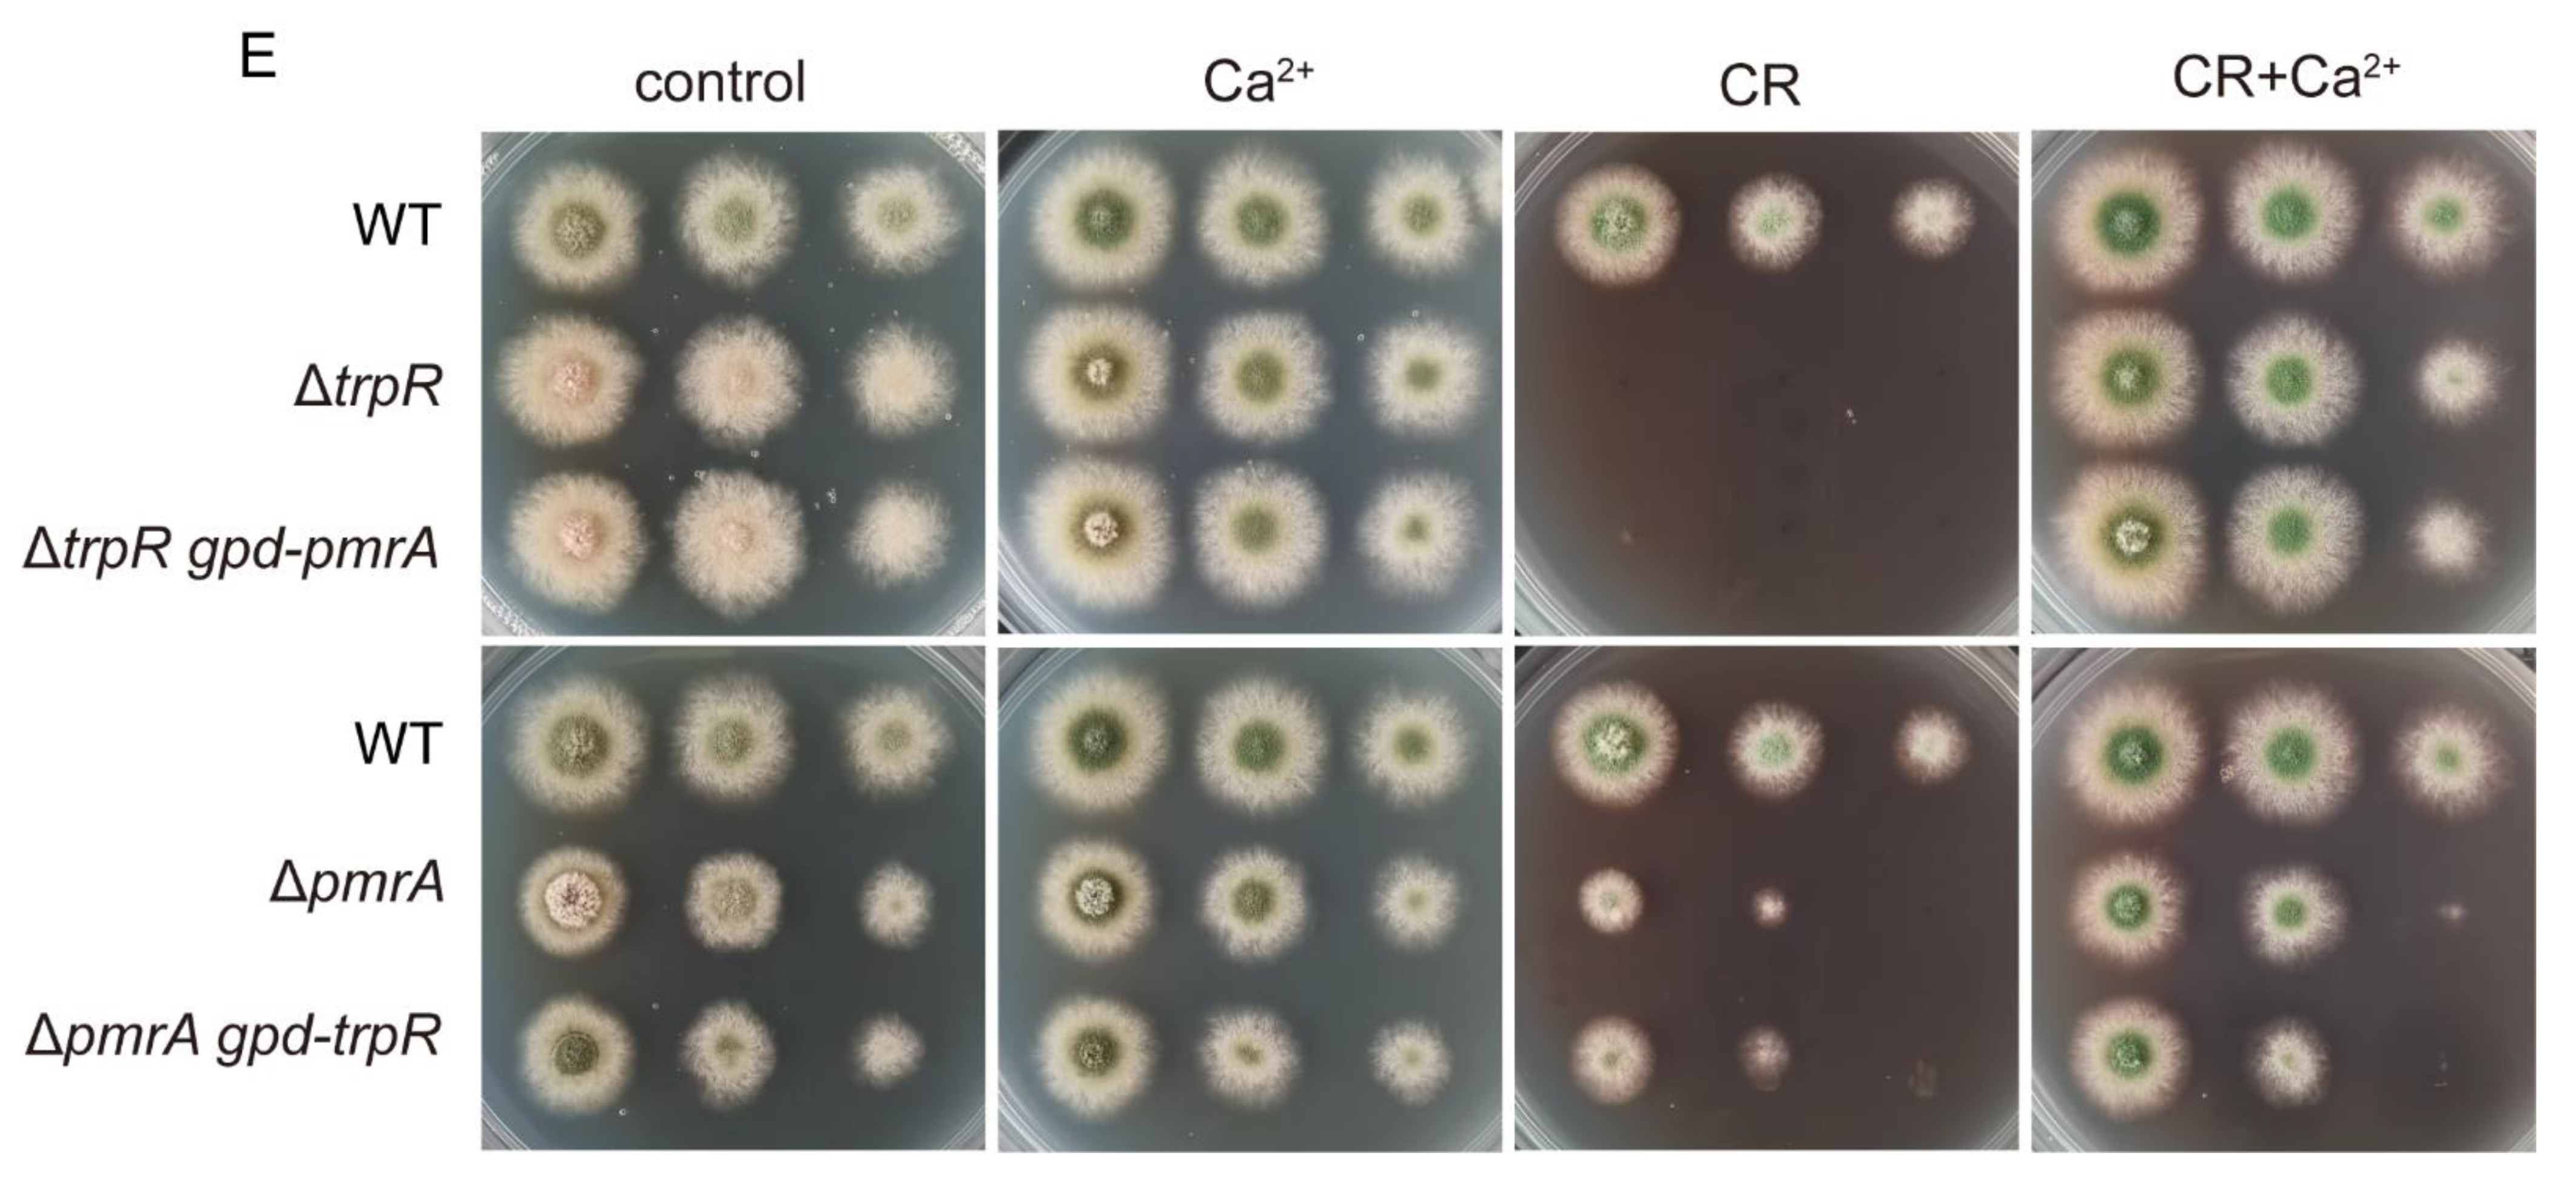
Jof 07 00920 g006b

A Transient Receptor Potential-like Calcium Ion Channel in the Filamentous Fungus Aspergillus nidulans
Abstract
:1. Introduction
2. Materials and Methods
2.1. Strains, Media, and Growth Conditions
2.2. Genetic Mutant Strain Construction
2.3. Phylogenetic Analysis
2.4. Plate
2.5. Microscopic Observation and Image Processing
2.6. RNA Isolation and Quantitative RT-PCR Assays
2.7. Cytoplasmic Ca2+ Measurement
2.8. Statistical Analysis
3. Results
3.1. Phylogenetic Evolution and Diversification of TrpR Homologs in Selected Eukaryotic Species
3.2. Dynamic Localization of TrpR-GFP during Different Developmental Stages of A. nidulans
3.3. Lack of TrpR Causes Hypersensitivity to Thermal Stresses and Cell Wall Destruction Reagents
3.4. Defects of the ΔtrpR Mutant Can Be Rescued by Adding Extracellular Ca2+
3.5. Genetic and Functional Relationship between TrpR and the Previously Identified High-Affinity Calcium Channels CchA/MidA
3.6. Lack of Golgi-Localized ATPase PmrA Severely Aggravates Defects of ΔtrpR
3.7. TrpR Is Involved in the Normal Cell Wall Architecture and Composition
4. Discussion
Supplementary Materials
Author Contributions
Funding
Institutional Review Board Statement
Informed Consent Statement
Data Availability Statement
Acknowledgments
Conflicts of Interest
References
- Cosens, D.J.; Manning, A. Abnormal electroretinogram from a Drosophila mutant. Nature 1969, 224, 285–287. [Google Scholar] [CrossRef]
- Samanta, A.; Hughes, T.E.T.; Moiseenkova-Bell, V.Y. Transient Receptor Potential (TRP) Channels. Subcell Biochem 2018, 87, 141–165. [Google Scholar] [PubMed]
- Pan, Z.; Yang, H.; Reinach, P.S. Transient receptor potential (TRP) gene superfamily encoding cation channels. Hum. Genom. 2011, 5, 108–116. [Google Scholar] [CrossRef] [Green Version]
- Wang, Y.; Bu, J.; Shen, H.; Li, H.; Wang, Z.; Chen, G. Targeting Transient Receptor Potential Canonical Channels for Diseases of the Nervous System. Curr. Drug Targets 2017, 18, 1460–1465. [Google Scholar] [CrossRef]
- Kadowaki, T. Evolutionary dynamics of metazoan TRP channels. Pflugers Arch 2015, 467, 2043–2053. [Google Scholar] [CrossRef]
- Venkatachalam, K.; Montell, C. TRP channels. Annu. Rev. Biochem. 2007, 76, 387–417. [Google Scholar] [CrossRef] [PubMed] [Green Version]
- Morelli, M.B.; Amantini, C.; Liberati, S.; Santoni, M.; Nabissi, M. TRP channels: New potential therapeutic approaches in CNS neuropathies. CNS Neurol Disord. Drug Targets 2013, 12, 274–293. [Google Scholar] [CrossRef]
- Hardie, R.C. A brief history of trp: Commentary and personal perspective. Pflugers Arch 2011, 461, 493–498. [Google Scholar] [CrossRef]
- Palmer, C.P.; Zhou, X.L.; Lin, J.; Loukin, S.H.; Kung, C.; Saimi, Y. A TRP homolog in Saccharomyces cerevisiae forms an intracellular Ca(2+)-permeable channel in the yeast vacuolar membrane. Proc. Natl. Acad. Sci. USA 2001, 98, 7801–7805. [Google Scholar] [CrossRef] [PubMed] [Green Version]
- Zhou, X.L.; Batiza, A.F.; Loukin, S.H.; Palmer, C.P.; Kung, C.; Saimi, Y. The transient receptor potential channel on the yeast vacuole is mechanosensitive. Proc. Natl. Acad. Sci. USA 2003, 100, 7105–7110. [Google Scholar] [CrossRef] [Green Version]
- Zhou, X.; Su, Z.; Anishkin, A.; Haynes, W.J.; Friske, E.M.; Loukin, S.H.; Kung, C.; Saimi, Y. Yeast screens show aromatic residues at the end of the sixth helix anchor transient receptor potential channel gate. Proc. Natl. Acad. Sci. USA 2007, 104, 15555–15559. [Google Scholar] [CrossRef] [PubMed] [Green Version]
- Amini, M.; Chang, Y.; Wissenbach, U.; Flockerzi, V.; Schlenstedt, G.; Beck, A. Activity of the yeast vacuolar TRP channel TRPY1 is inhibited by Ca(2+)-calmodulin binding. J. Biol. Chem. 2021, 297, 101126. [Google Scholar] [CrossRef]
- Ma, Y.; Sugiura, R.; Koike, A.; Ebina, H.; Sio, S.O.; Kuno, T. Transient receptor potential (TRP) and Cch1-Yam8 channels play key roles in the regulation of cytoplasmic Ca2+ in fission yeast. PLoS ONE 2011, 6, e22421. [Google Scholar] [CrossRef] [Green Version]
- Ahmed, T.; Nisler, C.R.; Fluck, E.C., 3rd; Walujkar, S.; Sotomayor, M.; Moiseenkova-Bell, V.Y. Structure of the ancient TRPY1 channel from Saccharomyces cerevisiae reveals mechanisms of modulation by lipids and calcium. Structure 2021, in press. [Google Scholar] [CrossRef]
- Aydar, E.; Palmer, C.P. Polycystic kidney disease channel and synaptotagmin homologues play roles in schizosaccharomyces pombe cell wall synthesis/repair and membrane protein trafficking. J. Membr. Biol. 2009, 229, 141–152. [Google Scholar] [CrossRef]
- Morris, Z.; Sinha, D.; Poddar, A.; Morris, B.; Chen, Q. Fission yeast TRP channel Pkd2p localizes to the cleavage furrow and regulates cell separation during cytokinesis. Mol. Biol. Cell 2019, 30, 1791–1804. [Google Scholar] [CrossRef] [PubMed]
- Rigamonti, M.; Groppi, S.; Belotti, F.; Ambrosini, R.; Filippi, G.; Martegani, E.; Tisi, R. Hypotonic stress-induced calcium signaling in Saccharomyces cerevisiae involves TRP-like transporters on the endoplasmic reticulum membrane. Cell Calcium 2015, 57, 57–68. [Google Scholar] [CrossRef] [Green Version]
- Giorgi, C.; Romagnoli, A.; Pinton, P.; Rizzuto, R. Ca2+ signaling, mitochondria and cell death. Curr. Mol. Med. 2008, 8, 119–130. [Google Scholar] [PubMed]
- Zhang, Y.; Zheng, Q.; Sun, C.; Song, J.; Gao, L.; Zhang, S.; Munoz, A.; Read, N.D.; Lu, L. Palmitoylation of the Cysteine Residue in the DHHC Motif of a Palmitoyl Transferase Mediates Ca2+ Homeostasis in Aspergillus. PLoS Genet. 2016, 12, e1005977. [Google Scholar] [CrossRef] [PubMed] [Green Version]
- Zhang, S.; Zheng, H.; Long, N.; Carbo, N.; Chen, P.; Aguilar, P.S.; Lu, L. FigA, a putative homolog of low-affinity calcium system member Fig1 in Saccharomyces cerevisiae, is involved in growth and asexual and sexual development in Aspergillus nidulans. Eukaryot. Cell 2014, 13, 295–303. [Google Scholar] [CrossRef] [Green Version]
- Wang, S.; Cao, J.; Liu, X.; Hu, H.; Shi, J.; Zhang, S.; Keller, N.P.; Lu, L. Putative calcium channels CchA and MidA play the important roles in conidiation, hyphal polarity and cell wall components in Aspergillus nidulans. PLoS ONE 2012, 7, e46564. [Google Scholar] [CrossRef] [Green Version]
- Wang, S.; Liu, X.; Qian, H.; Zhang, S.; Lu, L. Calcineurin and Calcium Channel CchA Coordinate the Salt Stress Response by Regulating Cytoplasmic Ca2+ Homeostasis in Aspergillus nidulans. Appl. Environ. Microbiol. 2016, 82, 3420–3430. [Google Scholar] [CrossRef] [Green Version]
- Zelter, A.; Bencina, M.; Bowman, B.J.; Yarden, O.; Read, N.D. A comparative genomic analysis of the calcium signaling machinery in Neurospora crassa, Magnaporthe grisea, and Saccharomyces cerevisiae. Fungal Genet. Biol. 2004, 41, 827–841. [Google Scholar] [CrossRef]
- Jiang, H.; Liu, F.; Zhang, S.; Lu, L. Putative PmrA and PmcA are important for normal growth, morphogenesis and cell wall integrity, but not for viability in Aspergillus nidulans. Microbiology (Reading) 2014, 160 Pt 11, 2387–2395. [Google Scholar] [CrossRef] [PubMed]
- Weichert, M.; Guirao-Abad, J.; Aimanianda, V.; Krishnan, K.; Grisham, C.; Snyder, P.; Sheehan, A.; Abbu, R.R.; Liu, H.; Filler, S.G.; et al. Functional Coupling between the Unfolded Protein Response and Endoplasmic Reticulum/Golgi Ca(2+)-ATPases Promotes Stress Tolerance, Cell Wall Biosynthesis, and Virulence of Aspergillus fumigatus. mBio 2020, 11, 11. [Google Scholar] [CrossRef]
- Todd, R.B.; Davis, M.A.; Hynes, M.J. Genetic manipulation of Aspergillus nidulans: Meiotic progeny for genetic analysis and strain construction. Nat. Protoc. 2007, 2, 811–821. [Google Scholar] [CrossRef] [PubMed]
- Szewczyk, E.; Nayak, T.; Oakley, C.E.; Edgerton, H.; Xiong, Y.; Taheri-Talesh, N.; Osmani, S.A.; Oakley, B.R. Fusion PCR and gene targeting in Aspergillus nidulans. Nat. Protoc. 2006, 1, 3111–3120. [Google Scholar] [CrossRef]
- Zhang, S.; Zheng, H.; Chen, Q.; Chen, Y.; Wang, S.; Lu, L.; Zhang, S. The Lectin Chaperone Calnexin Is Involved in the Endoplasmic Reticulum Stress Response by Regulating Ca(2+) Homeostasis in Aspergillus nidulans. Appl. Environ. Microbiol. 2017, 83, e00673-17. [Google Scholar] [CrossRef] [Green Version]
- Nelson, G.; Kozlova-Zwinderman, O.; Collis, A.J.; Knight, M.R.; Fincham, J.R.; Stanger, C.P.; Renwick, A.; Hessing, J.G.; Punt, P.J.; van den Hondel, C.A.; et al. Calcium measurement in living filamentous fungi expressing codon-optimized aequorin. Mol. Microbiol. 2004, 52, 1437–1450. [Google Scholar] [CrossRef] [PubMed]
- Todd, R.B.; Davis, M.A.; Hynes, M.J. Genetic manipulation of Aspergillus nidulans: Heterokaryons and diploids for dominance, complementation and haploidization analyses. Nat. Protoc. 2007, 2, 822–830. [Google Scholar] [CrossRef] [PubMed]
- Li, D.; Liu, P.; Yu, J.; Wang, L.; Dossa, K.; Zhang, Y.; Zhou, R.; Wei, X.; Zhang, X. Genome-wide analysis of WRKY gene family in the sesame genome and identification of the WRKY genes involved in responses to abiotic stresses. BMC Plant. Biol. 2017, 17, 152. [Google Scholar] [CrossRef]
- Greene, V.; Cao, H.; Schanne, F.A.; Bartelt, D.C. Oxidative stress-induced calcium signalling in Aspergillus nidulans. Cell Signal 2002, 14, 437–443. [Google Scholar] [CrossRef]
- Montell, C. Physiology, phylogeny, and functions of the TRP superfamily of cation channels. Sci STKE 2001, 2001, re1. [Google Scholar] [CrossRef] [PubMed]
- Montell, C. The TRP superfamily of cation channels. Sci. STKE 2005, 2005, re3. [Google Scholar] [CrossRef] [Green Version]
- Liao, J.X.; Yin, Z.X.; Huang, X.D.; Weng, S.P.; Yu, X.Q.; He, J.G. Cloning and characterization of a shrimp ML superfamily protein. Fish Shellfish. Immunol. 2011, 30, 713–719. [Google Scholar] [CrossRef]
- Inohara, N.; Nunez, G. ML—A conserved domain involved in innate immunity and lipid metabolism. Trends Biochem. Sci. 2002, 27, 219–221. [Google Scholar] [CrossRef]
- Jerala, R. Structural biology of the LPS recognition. Int. J. Med. Microbiol. 2007, 297, 353–363. [Google Scholar] [CrossRef]
- Tisi, R.; Rigamonti, M.; Groppi, S.; Belotti, F. Calcium homeostasis and signaling in fungi and their relevance for pathogenicity of yeasts and filamentous fungi. Aims Mol. Sci. 2016, 3, 505–549. [Google Scholar] [CrossRef]
- de Castro, P.A.; Colabardini, A.C.; Manfiolli, A.O.; Chiaratto, J.; Silva, L.P.; Mattos, E.C.; Palmisano, G.; Almeida, F.; Persinoti, G.F.; Ries, L.N.A.; et al. Aspergillus fumigatus calcium-responsive transcription factors regulate cell wall architecture promoting stress tolerance, virulence and caspofungin resistance. PLoS Genet. 2019, 15, e1008551. [Google Scholar] [CrossRef] [PubMed] [Green Version]
- Valero, C.; Colabardini, A.C.; Chiaratto, J.; Pardeshi, L.; de Castro, P.A.; Ferreira Filho, J.A.; Silva, L.P.; Rocha, M.C.; Malavazi, I.; Costa, J.H.; et al. Aspergillus fumigatus Transcription Factors Involved in the Caspofungin Paradoxical Effect. mBio 2020, 11, 11. [Google Scholar] [CrossRef] [PubMed]
- Fujiwara, Y.; Minor, D.L., Jr. X-ray crystal structure of a TRPM assembly domain reveals an antiparallel four-stranded coiled-coil. J. Mol. Biol. 2008, 383, 854–870. [Google Scholar] [CrossRef] [PubMed] [Green Version]
- Komiya, Y.; Runnels, L.W. TRPM channels and magnesium in early embryonic development. Int. J. Dev. Biol. 2015, 59, 281–288. [Google Scholar] [CrossRef] [PubMed]

| Strains | Genotype | Source |
|---|---|---|
| TN02A7 | pyrG89; pyroA4; nkuA::argB2; riboB2; veA1 | FGSC |
| TrpR-GFP | pyrG89; pyroA4; nkuA::argB2; trpR::gfp-pyrG; riboB2; veA1 | This study |
| TrpR-GFP mRFP-PHOSBP | pyrG89; pyroA4; nkuA::argB2; trpR::gfp-pyrG; riboB2; veA1; gpd-mRFP-PHOSBP; | This study |
| TrpR-GFP RFP-PmrA | pyrG89; pyroA4; nkuA::argB2; trpR::gfp-pyrG;gpd::RFP::PmrA; riboB2; veA1; | This study |
| ΔtrpR | pyrG89; pyroA4; nkuA::argB2; ΔtrpR::pyrG; riboB2; veA1 | This study |
| ΔtrpR::pyroA | pyrG89; pyroA4; nkuA::argB2; ΔtrpR::pyroA; riboB2; veA1 | This study |
| ΔcchA | pyrG89; pyroA4; nkuA::argB2; ΔcchA::pyrG; riboB2; veA1 | [21] |
| ΔmidA | pyrG89; pyroA4; nkuA::argB2; ΔmidA::pyrG; riboB2; veA1 | [21] |
| ΔpmrA | pyrG89; pyroA4; nkuA::argB2; ΔpmrA::pyroA; riboB2; veA1 | [24] |
| ΔtrpRΔcchA | pyrG89; pyroA4; nkuA::argB2; ΔtrpR::pyrG; ΔcchA::pyroA; riboB2; veA1 | This study |
| ΔtrpRΔmidA | pyrG89; pyroA4; nkuA::argB2; ΔtrpR::pyroA; ΔmidA::pyrG; riboB2; veA1 | This study |
| TN02A7-AEQ | pyrG89; pyroA4; nkuA::argB2; veA1; pAEQ | This study |
| ΔtrpR-AEQ | pyrG89; pyroA4; ΔtrpR::pyrG; nkuA::argB2; veA1; pAEQ | This study |
| ΔcchA-AEQ | pyrG89; pyroA4; ΔcchA::pyrG; nkuA::argB2; veA1; pAEQ | This study |
| ΔtrpRΔcchA-AEQ | pyrG89; pyroA4; ΔtrpR::pyroA; ΔcchA::pyrG; nkuA::argB2; veA1; pAEQ | This study |
| ΔpmrA-AEQ | pyrG89; pyroA4; ΔpmrA::pyrG; nkuA::argB2; veA1; pAEQ | This study |
| ΔtrpRΔpmrA-AEQ | pyrG89; pyroA4; ΔtrpR::pyroA; ΔpmrA::pyrG; nkuA::argB2; veA1; pAEQ | This study |
| ΔpmrA gpd-trpR | pyrG89; pyroA4; ΔpmrA::pyroA; pyrG-gpd-trpR; nkuA::argB2; veA1; | This study |
| ΔtrpR gpd-pmrA | pyrG89; pyroA4; ΔtrpR::pyroA; pyrG-gpd-pmrA; nkuA::argB2; veA1; | This study |
| Primer Names | Sequence 5′ to 3′ |
|---|---|
| trpR P1 | AGGGCGGTTGTTGATACGCT |
| trpR P3 | AAGAGCATTGTTTGAGGCCGCGACCTTTCTATATGAATG |
| trpR P4 | CTTGGCATCACGCATCAGTAGGCTCTCGCATTTCTTC |
| trpR P6 | CATTTCGGCTCTACTGCTC |
| trpR P2 | CGGTCGCCTACTGATTCTC |
| trpR P5 | GGCGTAGACGGTGGGAAAT |
| trpR diag F | TAGCATTCCGACCCTTCCC |
| trpR diag R | GCCTTTCCCTTTATCCTTTG |
| pyrG diag F | AGAGTATGCGGCAAGTC |
| pyrG diag R | AAACCAGAAGAAACCTCCC |
| trpRc up | CTGTTACTGAGCGGTTCTGAG |
| trpRc down | GATGACATCTTGGCGCTGGTAG |
| trpR-gfp P1 | GAGAGAGATCCCACAGCCGA |
| trpR-gfp P3 | CCAGCGCCTGCACCAGCTCCTGTGTATCGTGAGGAAGC |
| trpR-gfp P4 | TCTGAGAGACGAATTGGCATTAGGCTCTCGCATTTCTTC |
| trpR-gfp P6 | CATTTCGGCTCTACTGCTC |
| trpR-gfp P2 | TAGACCTCGTAAACGGACTG |
| trpR-gfp P5 | GGCGTAGACGGTGGGAAAT |
| gfp diag R | CATTGAACACCATAGGTGA |
| PHosbp F | GCATGCGGAGAGACGGACG |
| PHosbp R | TCACGAATTCTTCTTCACAGC |
| gpd-rfp-pmrA up | CCTTTAATCAAGCTTATCGATATGAGAAATGTCAAGGTCCGC |
| gpd-rfp-pmrA down | CTCGAGGTCGACGGTATCGATCAGAGGCACTCTTCCGACCAGT |
| gfp up | GGAGCTGGTGCAGGCGCTGG |
| pyrG down | GCCTCAAACAATGCTCTTCA |
| gpd up | CCTTTAATCAAGCTTATCGAT |
| gpd down | CTCGAGGTCGACGGTATCGAT |
| gpd-trpR up | CCTTTAATCAAGCTTATCGATATGGATTTCGATTACAACGCGA |
| gpd-trpR down | CTCGAGGTCGACGGTATCGATTCATGTGTATCGTGAGGAAG |
| gpd-pmrA up | CCTTTAATCAAGCTTATCGATATGAGAAATGTCAAGGTCCGC |
| gpd-pmrA down | CTCGAGGTCGACGGTATCGATTTACACATTCACGCTATATCC |
| Aeq F | ATGACCTCCAAGCAGTAC |
| Aeq R | TTAGGGGACGGCACCGCCGTA |
| RT-tub F | GCCGGTATGGGTACTCTTTTG |
| RT-tub R | GTCTCATCGGAGTGCTCAACG |
| RT-trpR F | TGATGACCTACCCACCGTACTCTT |
| RT-trpR R | GGCTATTCCTGACGCTTGAACT |
| RT-pmrA F | GGCTTCGATTCCTCAAACAG |
| RT-pmrA R | AAACCCAACCGTAACCACAA |
Publisher’s Note: MDPI stays neutral with regard to jurisdictional claims in published maps and institutional affiliations. |
© 2021 by the authors. Licensee MDPI, Basel, Switzerland. This article is an open access article distributed under the terms and conditions of the Creative Commons Attribution (CC BY) license (https://creativecommons.org/licenses/by/4.0/).
Share and Cite
Wang, H.; Chen, Q.; Zhang, S.; Lu, L. A Transient Receptor Potential-like Calcium Ion Channel in the Filamentous Fungus Aspergillus nidulans. J. Fungi 2021, 7, 920. https://doi.org/10.3390/jof7110920
Wang H, Chen Q, Zhang S, Lu L. A Transient Receptor Potential-like Calcium Ion Channel in the Filamentous Fungus Aspergillus nidulans. Journal of Fungi. 2021; 7(11):920. https://doi.org/10.3390/jof7110920
Chicago/Turabian StyleWang, Hongchen, Qiuyi Chen, Shizhu Zhang, and Ling Lu. 2021. "A Transient Receptor Potential-like Calcium Ion Channel in the Filamentous Fungus Aspergillus nidulans" Journal of Fungi 7, no. 11: 920. https://doi.org/10.3390/jof7110920
APA StyleWang, H., Chen, Q., Zhang, S., & Lu, L. (2021). A Transient Receptor Potential-like Calcium Ion Channel in the Filamentous Fungus Aspergillus nidulans. Journal of Fungi, 7(11), 920. https://doi.org/10.3390/jof7110920






